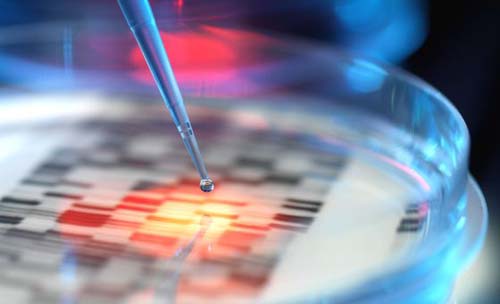

|
|
|
Mapa genético de toda la variabilidad
humana
El ADN proviene de 14 poblaciones de África, Asia Oriental, las dos Américas y Europa, incluidos los habitantes de la península Ibérica, y por primera vez la resolución es suficiente para capturar el 98% de las variantes genéticas que solo aparecen en el 1% de las personas. El esfuerzo internacional recibe el nombre de Proyecto 1.000 genomas, y aborda una cuestión fundamental para aplicar plenamente las tecnologías del ADN a la medicina: saber cuáles de las decenas o cientos de miles de variantes genéticas que todo individuo muestra respecto al genoma de referencia son relevantes para la medicina El genoma humano tiene cerca de 3 000 millones de bases, o letras del ADN. Este texto está incorporado dentro de cada una de nuestras células y determina las características normales de las células de nuestra especie. Sus variaciones son igualmente esenciales para el desarrollo de las enfermedades, desde la esclerosis múltiple hasta las dolencias cardiovasculares y el cáncer. El nuevo estudio de los 1.092 genomas es el primero con la potencia suficiente para hacer que afloren esas variantes presentes en menos del 1% de la población, y por ello servirá para que los investigadores puedan interpretar el genoma de cualquier paciente en el contexto de la variación genética típica de su propia población nacional. "Cada uno de nosotros es un experimento natural andante", explica el autor principal del estudio, el genetista Gil McVean de la Universidad de Oxford. "Algunos de nuestros genes están apagados, otros encendidos y otros hiperactivos; nuestro estudio muestra que toda persona aparentemente saludable lleva cientos de variantes genéticas raras que tienen un impacto significativo sobre la forma en que los genes funcionan, e incluso un puñado de cambios infrecuentes, entre dos y cinco, que ya se sabe por anteriores estudios que contribuyen a diversas enfermedades en otras personas". (El País) |
Solo
diez años después de haber presentado el genoma humano, un consorcio
mundial de científicos logró leer los genomas de 1 092 personas, en
lo que constituye el primer mapa genético exacto de casi toda la
variabilidad humana.
Solo
diez años después de haber presentado el genoma humano, un consorcio
mundial de científicos logró leer los genomas de 1 092 personas, en
lo que constituye el primer mapa genético exacto de casi toda la
variabilidad humana.